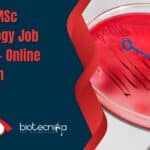
Freshers MSc Microbiology Job

Home Search
freshers - search results
If you're not happy with the results, please do another search
Biotecnika Times Newsletter 23.01.2023 DRDO Hiring, Freshers Jobs, DBT-BITP
Biotecnika Times Newsletter 23.03.2023 DRDO Hiring, Freshers Jobs, DBT-BITP
DRDO-DIPAS Hiring To Work In Futuristic Research Projects As JRFs, Attend Walk-In
DRDO-DIPAS Project JRF Jobs For...
Biotecnika Times Newsletter 17.01.2023 Freshers Jobs, Govt Internship, Ramalingaswamy Re-entry Fellowship
Biotecnika Times Newsletter 17.01.2023 Freshers Jobs, Govt Internship, Ramalingaswamy Re-entry Fellowship
Freshers Job Opening at SJRI For MSc Biotech, Life Sciences, Microbiology
Freshers Job Opening at...
Freshers Job Opening at SJRI For MSc Biotech, Life Sciences, Microbiology
Freshers Job Opening at SJRI For MSc Biotech, Life Sciences, Microbiology
Freshers Job Opening at SJRI For MSc Biotech, Life Sciences, Microbiology. MSc Biotech, Microbiology...
Biotecnika Times Newsletter 13.01.2023 Freshers Trainee Jobs, Apprentice Jobs
Biotecnika Times Newsletter 13.01.2023 Freshers Trainee Jobs, Apprentice Jobs
Freshers Trainee Biotech Job at Bharat Serums and Vaccines, Apply Online
Freshers Trainee Biotech Job at Bharat...
Freshers Trainee Biotech Job at Bharat Serums and Vaccines, Apply Online
Freshers Trainee Biotech Job at Bharat Serums and Vaccines, Apply Online
Freshers Trainee Biotech Job at Bharat Serums and Vaccines, Apply Online. BSV job opening...
Biotecnika Times Newsletter 12.01.2023 Govt MoEFCC Internship 2023, Freshers Job
Biotecnika Times Newsletter 12.01.2023 Govt MoEFCC Internship 2023, Freshers Job
Govt MoEF&CC Internship Scheme 2023 - Applications Invited Online
Govt MoEF&CC Internship 2023 - Applications Invited...
Freshers MSc Microbiology Job at Takeda – Online Application Process
Freshers MSc Microbiology Job at Takeda - Online Application Process
Freshers MSc Microbiology Job at Takeda - Online Application Process. MSc Microbiology job opening. Officer...
Reliance Research Assistant Job – Freshers Can Apply Online
Reliance Biology Freshrs Job. Reliance Industries Research Scientist For MSc Biology. MSc biology job opening 2022. Reliance is hiring biology freshers candidates. Freshers job...
Avantor Freshers Life Science / Biotech Job – Apply Online
Freshers Life Science Jobs. Freshers job opening 2022. Avantor Associate Life Science Job, MSc Apply Online. M.Sc. Life Sciences Jobs. Interested and eligible candidates...
Clarivate Freshers Job – Hiring Msc Candidates With 0-3 Years Experience – Apply Online
Freshers Msc Job. Clarivate Content Editor Job, 0-3 years experience Candidates Apply Online. MSc in Biotechnology, Microbiology, Life Sciences Job. Apply online for Associate...
NDDB Trainee Biotech, Botany, Zoology & Microbiology Job – Freshers Can Apply
NDDB Trainee Biotech, Botany, Zoology & Microbiology Job - Freshers Can Apply
NDDB Trainee Biotech, Botany, Zoology & Microbiology Job - Freshers Can Apply. Trainee...
Biotecnika Times Newsletter 03.11.2022 – Govt ILS, HPPSC Jobs, Freshers Jobs
Biotecnika Times Newsletter 03.11.2022 - Govt ILS, HPPSC Jobs, Freshers Jobs
Govt ILS Research Fellow Job For MSc Bioinformatics, Apply Online
ILS SRF 2022 Job Opening...
Freshers Vs Biotech Companies – Who Will Win?
Biotech freshers & Biotech Companies
Biotech freshers often complain they dont get jobs; there is no scope in Biotech, biotech companies don't hire freshers &...
Biotecnika Times Newsletter 17.10.2022 Freshers Jobs, Walk-In, Govt HPPSC Hiring
Biotecnika Times Newsletter 17.10.2022 Freshers Jobs, Walk-In, Govt HPPSC Hiring
Freshers Can Apply For Project Job at SJRI - Online Application Process
Freshers Microbiology Project Job...
Freshers Can Apply For Project Job at SJRI – Online Application Process
Freshers Microbiology Project Job Opening - Online Application Process
Freshers Microbiology Project Job Opening - Online Application Process. MSc Medical Microbiology and Genera Microbiology vacancy...